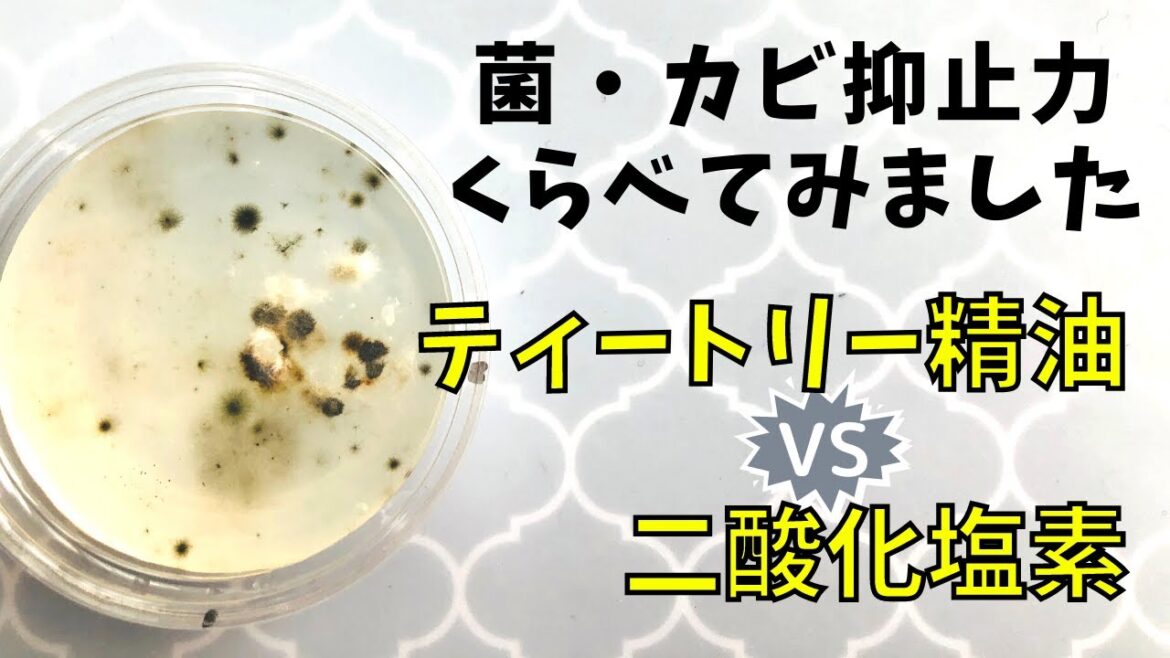
【アロマで抗菌って大丈夫⁈】二酸化塩素とティートリーの抑止力を比べてみた結果 【アロマで抗菌って大丈夫⁈】二酸化塩素とティートリーの抑止力を比べてみた結果

菌とカビの増殖実験しました。
水の消毒や除菌消臭剤として使われている『二酸化塩素』
昔は傷薬として使われていた『ティートリー』の精油。
どれくらい菌やカビの増殖を抑えることができたと思いますか?
★動画撮影のきっかけ★
『✖︎✖︎防止効果がある』という安易なキャッチが
実は危険な場合もあるので、
アロマセラピスト、インストラクターの皆さんも
気をつけましょう
公開中の関連動画
★【検証】メイクブラシやマスクの【菌・カビ】エタノールとティートリーで比べた結果

★【検証】日焼け止めは本当に効くのか?紫外線チェッカーで試してみた

ビューティープランナー・野村純子
◎エステティシャン歴20年以上
◎美容専門学校講師10年
◎日本エステティック業協会認定講師
◎インターナショナルエステティシャン
◎アロマテラピーインストラクター
愛知県尾張旭市・アロマ&エステSalon de Shuna
ブログ https://ameblo.jp/salon-shuna
★リアル講座お知らせ
2021年9月27日(月)10:30~12:00
生活の木/名古屋松坂屋店
「お客様とスタッフの健康を守る感染症対策」
サロン従事者、教室運営者のための講座、現在受付中です。
受講申し込みは生活の木ハーバルライフカレッジ公式サイト、
または052-242-2568(生活の木・名古屋松坂屋)へ。
講師:野村純子
受講料:2750円・教材300円
#エステティシャン向けレッスンはサロンドシュナで随時開催中です

3 Comments
自分も二酸化塩素を毎日飲んでます。
皮膚病も痒みなくなり最高です。
実証実験ありがとうございました。
実験、ありがとうございます。
一部のアロマやハーブが何にでも効く、科学や医療は有害とする信者に見せたい画像です。
二酸化塩素は毎日のんでます^^